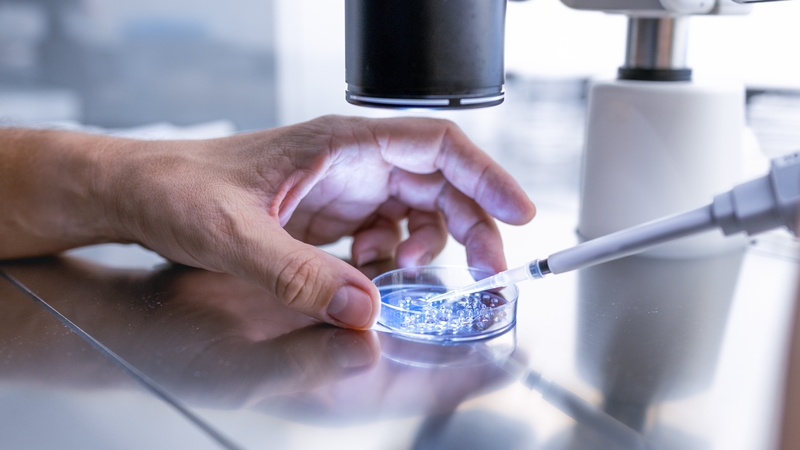
The State will also pay for embryos to be stored for up to two years under a new funding model starting today

A new publicly-funded fertility treatment scheme will include the transfer and storage of all embryos arising from one cycle of IVF, the Health Service Executive has confirmed.
Speaking to RTÉ’s Morning Ireland, Clinical Director of the HSE's National Women and Infants Health Programme Dr Cliona Murphy said: "A full publicly funded cycle of IVF will comprise of one episode of ovarian stimulation.
"That's developing the eggs and then transferring any resultant fresh or frozen embryos until such time as all embryos have been used - or the treatment results in a live birth.
"This means frozen embryos could be used in future attempts, so potentially somebody could get pregnant on the third try of that cycle."
Under the new funding model starting today, the State will also pay for embryos to be stored for up to two years.
Dr Murphy added: "In the event of a couple being successful and having a baby, their frozen embryos may be used by them - at their own cost – if they want to try for more children in the future."
Eligibility criteria for couples includes an age limit of 40 for women and 59 for men while intending mothers-to-be must have a BMI of no more than 30.
Couples who have previously had more than one round of IVF are also ruled out.
Among those hoping to avail of the new treatment is Clare, 26, who lives with her husband in Co Cavan. They have been trying to conceive, without success, for over two years.
Clare explains: "I have PCOS - polycystic ovarian syndrome - which can affect your chances of conception. And to find out I have this condition at such a young age is heartbreaking.
"Fertility treatment is such a huge expense - it would probably take a couple of years for us to save up for something like that.
"I think free treatment is such a great idea and I hope it makes a big difference to a lot of couples out there."
The pathway to fertility treatment for couples starts with a referral from their GP to a HSE Fertility Hub located at various hospitals nationwide.
If tests and investigations in the hub are not successful, the HSE will now fund further treatment at selected private fertility clinics nationwide.
They include ReproMed in Dublin and Galway which are already receiving plenty of inquiries from eligible couples, according to Medical Director Dr Hans Arce Sáenz.
He said treatments covered by the HSE will include intrauterine insemination (IUI) – where a sperm sample is injected into the womb around the time of ovulation.
"The next step would be IVF, which would be a more invasive treatment with better success rates."
Fertilisation takes places outside the body before being transferred back to the woman's womb.
"The third option is Intracytoplasmic sperm injection (ICSI) – which is similar to IVF but involves the injection of sperm directly into an egg and is aimed at couples with male fertility issues such as low sperm count," according to Dr Arce Sáenz.
He said prices typically started at €900 for IUI with one round of ICSI costing upwards of €5,700.
Free treatment in fertility clinics will not be offered to same-sex couples, single people or couples using donated eggs or sperm, under the new HSE scheme.
Minister for Health Stephen Donnelly has previously indicated that this is because the Assisted Human Reproduction legislation has yet to be approved in the Oireachtas.